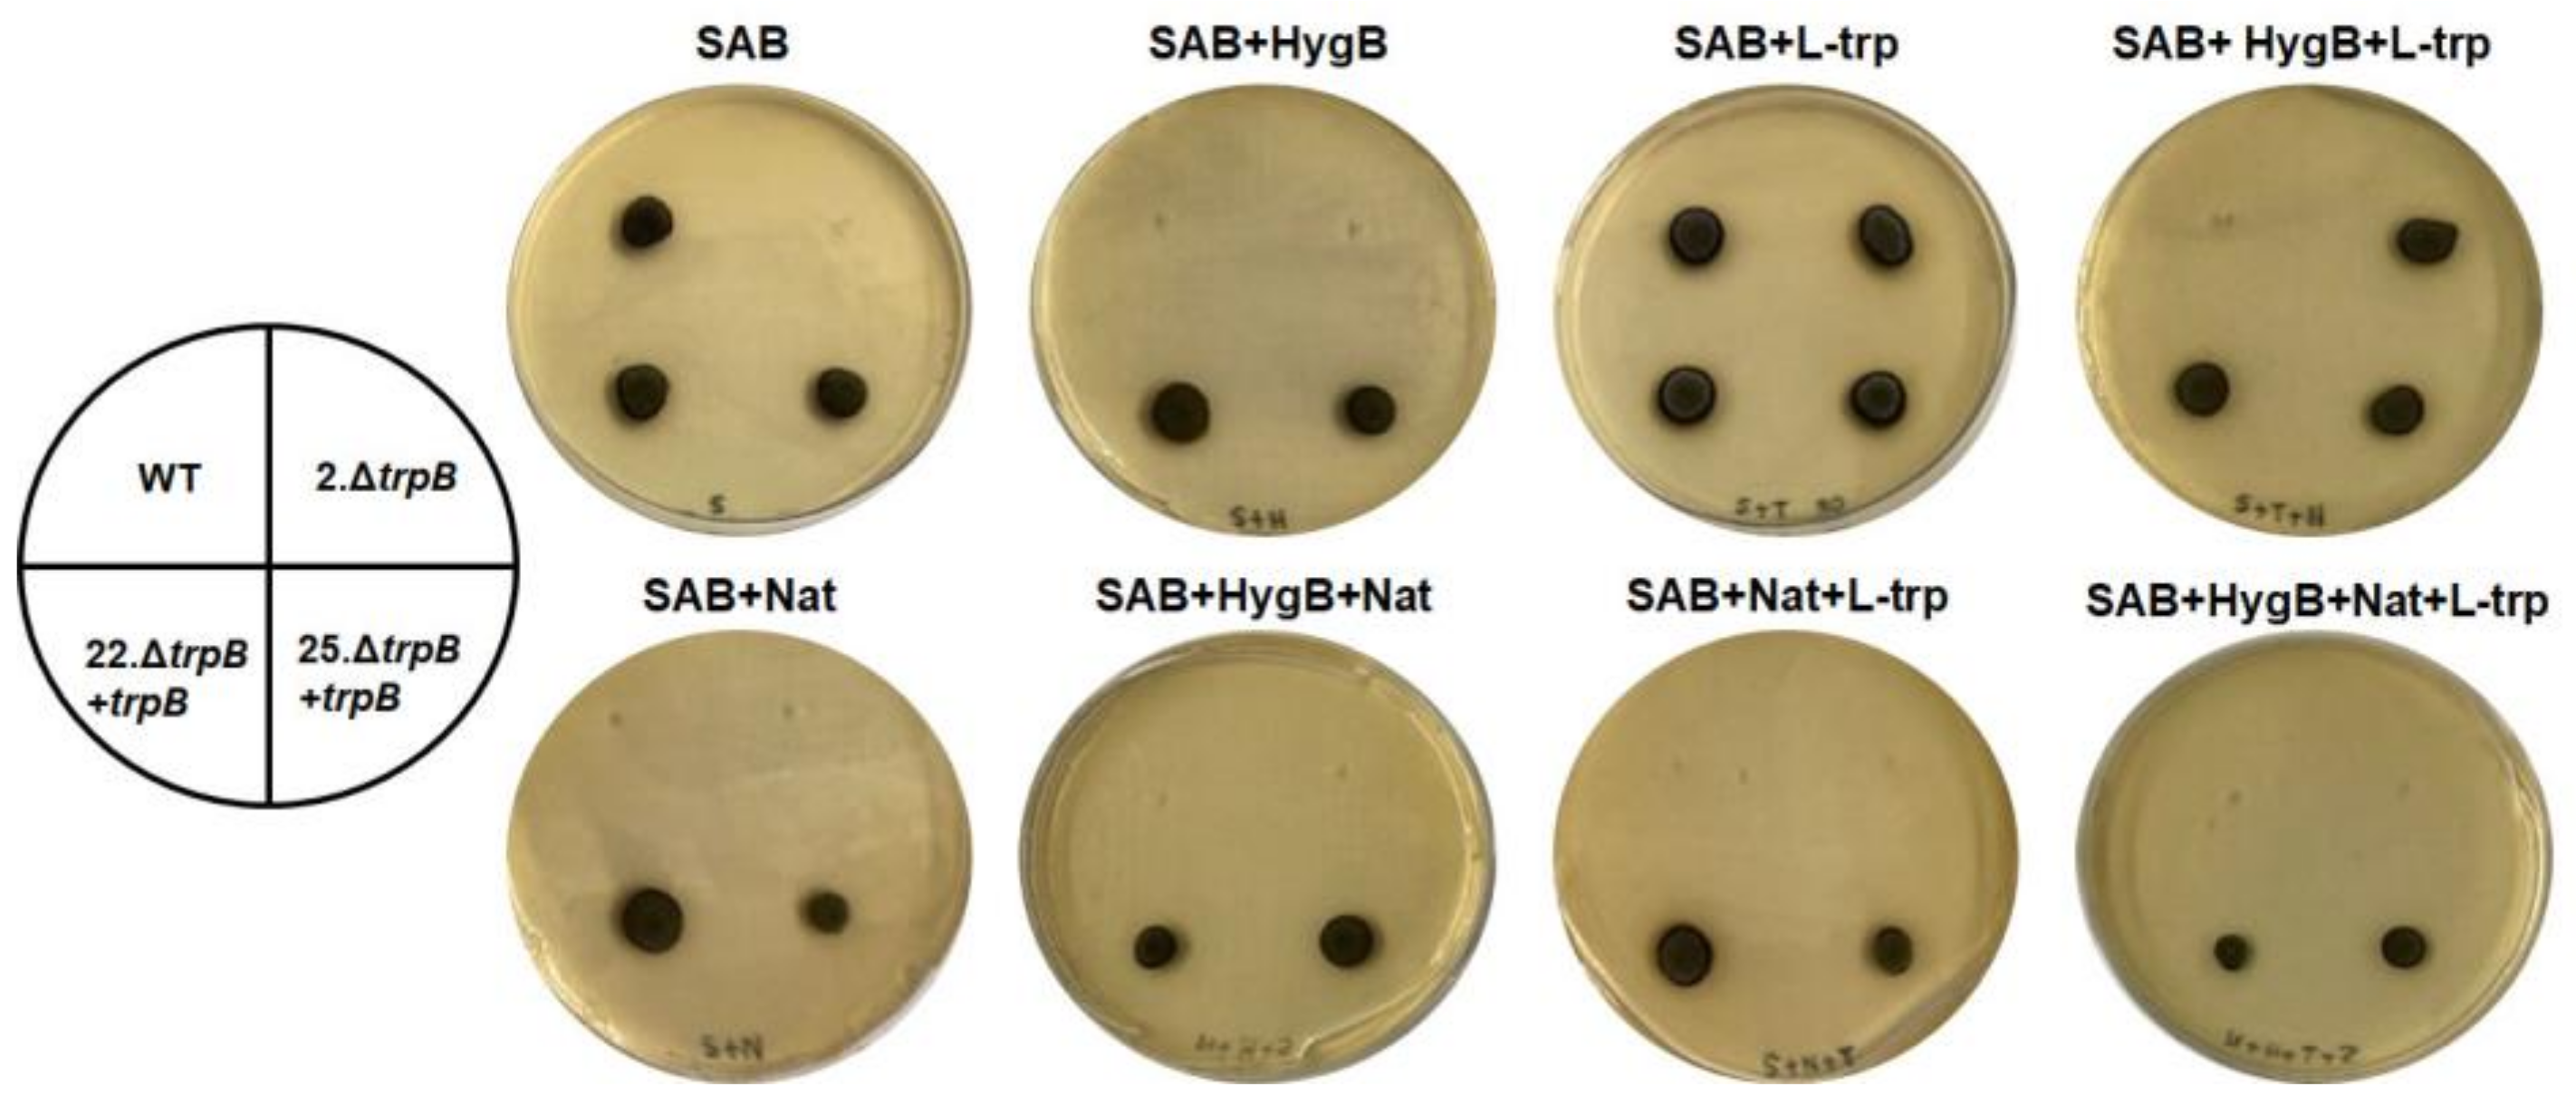
Jof 09 00224 g003 Jof 09 00224 g003

Expanding the Toolbox for Functional Genomics in Fonsecaea pedrosoi: The Use of Split-Marker and Biolistic Transformation for Inactivation of Tryptophan Synthase (trpB) Gene
Abstract
1. Introduction
2. Materials and Methods
2.1. Strains and Growth Conditions of F. pedrosoi
2.2. In Silico Search for Enzymes Related to Tryptophan Biosynthesis in F. pedrosoi and Evaluation of The trp Gene’s Expression
2.3. Construction of trpB Deletion Cassette by Double-Joint PCR (DJ-PCR)
2.4. Biolistics Transformation and Selection of trpB Mutant
2.5. PCR Confirmation of trpB Deletion
2.6. Southern Blotting
2.7. Evaluation of Tryptophan Concentration Required for ΔtrpB Growth
2.8. Radial Growth Measurement
2.9. Evaluation of Conidia Germination
2.10. Conidial Viability Assay
2.11. Determination of 5-Fluoroanthranilic Acid (5-FAA) Concentration for Selection of trp- and Counter-Selection of trp+
2.12. Gene Replacement Strategy
3. Results
3.1. Biosynthesis of Tryptophan in F. pedrosoi—An In Silico Analysis
3.2. Gene Disruption and Reconstitution in F. pedrosoi
3.3. External Supply of Tryptophan Is Required for Proper Growth of F. pedrosoi ΔtrpB
3.4. Deletion of trpB Causes Growth Delay and Viability Defects
3.5. trpB Deletion Induces 5-FAA Resistance in F. pedrosoi
4. Discussion
5. Conclusions
Supplementary Materials
Author Contributions
Funding
Institutional Review Board Statement
Informed Consent Statement
Data Availability Statement
Acknowledgments
Conflicts of Interest
References
- Santos, A.L.S.; Palmeira, V.F.; Rozental, S.; Kneipp, L.F.; Nimrichter, L.; Alviano, D.S.; Rodrigues, M.L.; Alviano, C.S. Biology and Pathogenesis of Fonsecaea pedrosoi, the Major Etiologic Agent of Chromoblastomycosis. FEMS Microbiol. Rev. 2007, 31, 570–591. [Google Scholar] [CrossRef] [PubMed]
- Queiroz-Telles, F.; Esterre, P.; Perez-Blanco, M.; Vitale, R.; Salgado, C.G.; Bonifaz, A. Chromoblastomycosis: An Overview of Clinical Manifestations, Diagnosis and Treatment. Med. Mycol. 2009, 47, 3–15. [Google Scholar] [CrossRef] [PubMed]
- Coelho, R.A.; Brito-Santos, F.; Figueiredo-Carvalho, M.H.G.; Silva, J.V.D.S.; Gutierrez-Galhardo, M.C.; do Valle, A.C.F.; Zancopé-Oliveira, R.M.; Trilles, L.; Meyer, W.; Freitas, D.F.S.; et al. Molecular Identification and Antifungal Susceptibility Profiles of Clinical Strains of Fonsecaea spp. Isolated from Patients with Chromoblastomycosis in Rio de Janeiro, Brazil. PLoS Negl. Trop. Dis. 2018, 12, 1–15. [Google Scholar] [CrossRef] [PubMed]
- Brito, A.C.D.; Bittencourt, M.D.J.S. Chromoblastomycosis: An Etiological, Epidemiological, Clinical, Diagnostic, and Treatment Update. An. Bras. Dermatol. 2018, 93, 495–506. [Google Scholar] [CrossRef]
- Santos, D.W.C.L.; de Azevedo, C.d.M.P.E.S.; Vicente, V.A.; Queiroz-Telles, F.; Rodrigues, A.M.; de Hoog, G.S.; Denning, D.W.; Colombo, A.L. The Global Burden of Chromoblastomycosis. PLoS Negl. Trop. Dis. 2021, 15, 1–26. [Google Scholar] [CrossRef]
- Bonifaz, A.; Carrasco-Gerard, E.; Saul, A. Chromoblastomycosis: Clinical and Mycologic Experience of 51 Cases. Mycoses 2001, 44, 1–7. [Google Scholar] [CrossRef]
- Esterre, P.; Andriantsimahavandy, A.; Ramarcel, E.R.; Pecarrere, J.-L. Forty Years of Chromoblastomycosis in Madagascar: A Review. Am. J. Trop. Med. Hyg. 1996, 55, 45–47. [Google Scholar] [CrossRef]
- Agarwal, R.; Singh, G.; Ghosh, A.; Verma, K.K.; Pandey, M.; Xess, I. Chromoblastomycosis in India: Review of 169 Cases. PLoS Negl. Trop. Dis. 2017, 11, e0005534. [Google Scholar] [CrossRef]
- Attapattu, M.C. Chromoblastomycosis—A Clinical and Mycological Study of 71 Cases from Sri Lanka. Mycopathologia 1997, 137, 145–151. [Google Scholar] [CrossRef]
- Gomes, R.R.; Vicente, V.A.; Azevedo, C.M.P.S.d.; Salgado, C.G.; da Silva, M.B.; Queiroz-Telles, F.; Marques, S.G.; Santos, D.W.C.L.; de Andrade, T.S.; Takagi, E.H.; et al. Molecular Epidemiology of Agents of Human Chromoblastomycosis in Brazil with the Description of Two Novel Species. PLoS Negl. Trop. Dis. 2016, 10, 1–20. [Google Scholar] [CrossRef]
- Silva, J.P.; De Souza, W.; Rozental, S. Chromoblastomycosis: A Retrospective Study of 325 Cases on Amazonic Region (Brazil). Mycopathologia 1998, 143, 171–175. [Google Scholar] [CrossRef]
- Queiroz-Telles, F.; de Hoog, S.; Santos, D.W.C.L.; Salgado, C.G.; Vicente, V.A.; Bonifaz, A.; Roilides, E.; Xi, L.; de Maria Pedrozo e Silva Azevedo, C.; da Silva, M.B.; et al. Chromoblastomycosis. Clin. Microbiol. Rev. 2017, 30, 233–276. [Google Scholar] [CrossRef]
- Gimenes, V.M.F.; Criado, P.R.; Martins, J.E.C.; Almeida, S.R. Cellular Immune Response of Patients with Chromoblastomycosis Undergoing Antifungal Therapy. Mycopathologia 2006, 162, 97–101. [Google Scholar] [CrossRef]
- Ameen, M. Chromoblastomycosis: Clinical Presentation and Management. Clin. Exp. Dermatol. 2009, 34, 849–854. [Google Scholar] [CrossRef]
- Alviano, C.S.; Farbiarz, S.R.; De Souza, W.; Angluster, J.; Travassos, L.R. Characterization of Fonsecaea pedrosoi Melanin. J. Gen. Microbiol. 1991, 137, 837–844. [Google Scholar] [CrossRef]
- Alviano, D.S.; Franzen, A.J.; Travassos, L.R.; Holandino, C.; Rozental, S.; Ejzemberg, R.; Alviano, C.S.; Rodrigues, M.L. Melanin from Fonsecaea pedrosoi Induces Production of Human Antifungal Antibodies and Enhances the Antimicrobial Efficacy of Phagocytes. Society 2004, 72, 229–237. [Google Scholar] [CrossRef]
- Cunha, M.M.L.; Franzen, A.J.; Alviano, D.S.; Zanardi, E.; Alviano, C.S.; De Souza, W.; Rozental, S. Inhibition of Melanin Synthesis Pathway by Tricyclazole Increases Susceptibility of Fonsecaea pedrosoi against Mouse Macrophages. Microsc. Res. Tech. 2005, 68, 377–384. [Google Scholar] [CrossRef]
- Cunha, M.M.; Franzen, A.J.; Seabra, S.H.; Herbst, M.H.; Vugman, N.V.; Borba, L.P.; de Souza, W.; Rozental, S. Melanin in Fonsecaea pedrosoi: A Trap for Oxidative Radicals. BMC Microbiol. 2010, 10, 80. [Google Scholar] [CrossRef]
- Bocca, A.L.; Brito, P.P.M.S.; Figueiredo, F.; Tosta, C.E. Inhibition of Nitric Oxide Production by Macrophages in Chromoblastomycosis: A Role for Fonsecaea pedrosoi Melanin. Mycopathologia 2006, 161, 195–203. [Google Scholar] [CrossRef]
- Pinto, L.; Granja, L.F.Z.; Alviano, D.S.; da Silva, M.H.; Alviano, C.S.; Ejzemberg, R. Activation of the Human Complement System by Pigmented and Hypopigmented Mycelia of the Fungus Fonsecaea pedrosoi. Mycoses 2011, 54, 474–480. [Google Scholar] [CrossRef]
- Pinto, L.; Granja, L.F.Z.; Almeida, M.A.d.; Alviano, D.S.; Silva, M.H.D.; Ejzemberg, R.; Rozental, S.; Alviano, C.S. Melanin Particles Isolated from the Fungus Fonsecaea pedrosoi Activates the Human Complement System. Mem. Inst. Oswaldo Cruz 2018, 8, 113. [Google Scholar] [CrossRef] [PubMed]
- Gómez, B.L.; Nosanchuk, J.D. Melanin and Fungi. Curr. Opin. Infect. Dis. 2003, 16, 91–96. [Google Scholar] [CrossRef] [PubMed]
- Chongkae, S.; Nosanchuk, J.D.; Pruksaphon, K.; Laliam, A.; Pornsuwan, S.; Youngchim, S. Production of Melanin Pigments in Saprophytic Fungi in Vitro and during Infection. J. Basic Microbiol. 2019, 59, 1092–1104. [Google Scholar] [CrossRef] [PubMed]
- Xiao, X.; Li, Y.; Lan, Y.; Zhang, J.; He, Y.; Cai, W.; Chen, Z.; Xi, L.; Zhang, J. Deletion of PksA Attenuates the Melanogenesis, Growth and Sporulation Ability and Causes Increased Sensitivity to Stress Response and Antifungal Drugs in the Human Pathogenic Fungus Fonsecaea monophora. Microbiol. Res. 2021, 244, 126668. [Google Scholar] [CrossRef]
- Li, M.; Huang, H.; Liu, J.; Zhang, X.; Li, Q.; Li, D.; Luo, M.; Wang, X.; Zeng, W.; Sun, J.; et al. Deletion C-Terminal Thioesterase Abolishes Melanin Biosynthesis, Affects Metabolism and Reduces the Pathogenesis of Fonsecaea monophora. PLoS Negl. Trop. Dis. 2022, 16, 1–25. [Google Scholar] [CrossRef]
- Siqueira, I.M.; Wüthrich, M.; Li, M.; Wang, H.; Las-Casas, L.d.O.; de Castro, R.J.A.; Klein, B.; Bocca, A.L. Early Immune Response against Fonsecaea Pedrosoi Requires Dectin-2-Mediated Th17 Activity, Whereas Th1 Response, Aided by Treg Cells, Is Crucial for Fungal Clearance in Later Stage of Experimental Chromoblastomycosis. PLoS Negl. Trop. Dis. 2020, 14, e0008386. [Google Scholar] [CrossRef]
- Wüthrich, M.; Wang, H.; Li, M.; Lerksuthirat, T.; Hardison, S.E.; Brown, G.D.; Klein, B. Fonsecaea pedrosoi -Induced Th17-Cell Differentiation in Mice Is Fostered by Dectin-2 and Suppressed by Mincle Recognition. Eur. J. Immunol. 2015, 45, 2542–2552. [Google Scholar] [CrossRef]
- Castro, R.J.A.D.; Siqueira, I.M.; Jerônimo, M.S.; Basso, A.M.M.; Veloso Junior, P.H.D.H.; Magalhães, K.G.; Leonhardt, L.C.; Oliveira, S.A.M.D.; Bürgel, P.H.; Tavares, A.H.; et al. The Major Chromoblastomycosis Etiologic Agent Fonsecaea pedrosoi Activates the NLRP3 Inflammasome. Front. Immunol. 2017, 8, 1572. [Google Scholar] [CrossRef]
- Machado, A.P.; Regis Silva, M.R.; Fischman, O. Local Phagocytic Responses after Murine Infection with Different Forms of Fonsecaea pedrosoi and Sclerotic Bodies Originating from an Inoculum of Conidiogenous Cells. Mycoses 2011, 54, 202–211. [Google Scholar] [CrossRef]
- Siqueira, I.M.; de Castro, R.J.A.; Leonhardt, L.C.d.M.; Jerônimo, M.S.; Soares, A.C.; Raiol, T.; Nishibe, C.; Almeida, N.; Tavares, A.H.; Hoffmann, C.; et al. Modulation of the Immune Response by Fonsecaea pedrosoi Morphotypes in the Course of Experimental Chromoblastomycosis and Their Role on Inflammatory Response Chronicity. PLoS Negl. Trop. Dis. 2017, 11, e0005461. [Google Scholar] [CrossRef]
- Alviano, C.S.; Farbiarz, S.R.; Travassos, L.R.; Angluster, J.; de Souza, W. Effect of Environmental Factors on Fonsecaea pedrosoi Morphogenesis with Emphasis on Sclerotic Cells Induced by Propranolol. Mycopathologia 1992, 119, 17–23. [Google Scholar] [CrossRef]
- Alviano, D.S.; Kneipp, L.F.; Lopes, A.H.; Travassos, L.R.; Meyer-Fernandes, J.R.; Rodrigues, M.L.; Alviano, C.S. Differentiation of Fonsecaea pedrosoi Mycelial Forms into Sclerotic Cells Is Induced by Platelet-Activating Factor. Res. Microbiol. 2003, 154, 689–695. [Google Scholar] [CrossRef]
- Dong, B.; Tong, Z.; Li, R.; Chen, S.C.A.; Liu, W.; Liu, W.; Chen, Y.; Zhang, X.; Duan, Y.; Li, D.; et al. Transformation of Fonsecaea pedrosoi into Sclerotic Cells Links to the Refractoriness of Experimental Chromoblastomycosis in BALB/c Mice via a Mechanism Involving a Chitin-Induced Impairment of IFN-γ Production. PLoS Negl. Trop. Dis. 2018, 12, 1–31. [Google Scholar] [CrossRef]
- Las-Casas, L.d.O.; Marina, C.L.F.; de Castro, R.J.A.; Coelho, L.C.; Báo, S.N.; de Hoog, G.S.; Vicente, V.A.; Fernandes, L.; Bocca, A.L. Pathogenicity and Growth Conditions Modulate Fonsecaea Extracellular Vesicles’ Ability to Interact With Macrophages. Front. Cell. Infect. Microbiol. 2022, 12, 1–14. [Google Scholar] [CrossRef]
- Florencio, C.S.; Brandão, F.A.S.; Teixeira, M.d.M.; Bocca, A.L.; Felipe, M.S.S.; Vicente, V.A.; Fernandes, L. Genetic Manipulation of Fonsecaea pedrosoi Using Particles Bombardment and Agrobacterium Mediated Transformation. Microbiol. Res. 2018, 207, 269–279. [Google Scholar] [CrossRef]
- Lynch, J.H.; Dudareva, N. Aromatic Amino Acids: A Complex Network Ripe for Future Exploration. Trends Plant Sci. 2020, 25, 670–681. [Google Scholar] [CrossRef]
- Hutter, R.; Niederberger, P.; DeMoss, J.A. Tryptophan Biosynthetic Genes in Eukaryotic Microorganisms. Annu. Rev. Microbiol. 1986, 40, 55–77. [Google Scholar] [CrossRef]
- Bentley, R.; Haslam, E. The Shikimate Pathway—A Metabolic Tree with Many Branche. Crit. Rev. Biochem. Mol. Biol. 1990, 25, 307–384. [Google Scholar] [CrossRef]
- Herrmann, K.M.; Weaver, L.M. The Shikimate Pathway. Annu. Rev. Plant Physiol. Plant Mol. Biol. 1999, 50, 473–503. [Google Scholar] [CrossRef]
- Comai, S.; Bertazzo, A.; Brughera, M.; Crotti, S. Tryptophan in Health and Disease. Adv. Clin. Chem. 2020, 95, 165–218. [Google Scholar] [CrossRef]
- Ren, W.; Bin, P.; Yin, Y.; Wu, G. Impacts of Amino Acids on the Intestinal Defensive System. Adv. Exp. Med. Biol. 2020, 1265, 133–151. [Google Scholar] [CrossRef] [PubMed]
- Yanofsky, C. Comparison of Regulatory and Structural Regions of Genes of Tryptophan Metabolism. Mol. Biol. Evol. 1984, 1, 143–161. [Google Scholar] [CrossRef] [PubMed]
- Burns, D.M.; Horn, V.; Paluh, J.Y.C. Evolution of the Tryptophan Synthetase of Fungi. Analysis of Experimentally Fused Escherichia Coli Tryptophan Synthetase Alpha and Beta Chains. Biochemistry 1990, 265, 2060–2069. [Google Scholar] [CrossRef]
- Burns, D.M.; Yanofsky, C. Nucleotide Sequence of the Neurospora Crassa Trp-3 Gene Encoding Tryptophan Synthetase and Comparison of the Trp-3 Polypeptide with Its Homologs in Saccharomyces Cerevisiae and Escherichia Coli. J. Biol. Chem. 1989, 264, 3840–3848. [Google Scholar] [CrossRef] [PubMed]
- Dunn, M.F.; Niks, D.; Ngo, H.; Barends, T.R.M.; Schlichting, I. Tryptophan Synthase: The Workings of a Channeling Nanomachine. Trends Biochem. Sci. 2008, 33, 254–264. [Google Scholar] [CrossRef]
- Fleming, J.R.; Schupfner, M.; Busch, F.; Baslé, A.; Ehrmann, A.; Sterner, R.; Mayans, O. Evolutionary Morphing of Tryptophan Synthase: Functional Mechanisms for the Enzymatic Channeling of Indole. J. Mol. Biol. 2018, 430, 5066–5079. [Google Scholar] [CrossRef]
- Braus, G.H. Aromatic Amino Acid Biosynthesis in the Yeast Saccharomyces cerevisiae: A Model System for the Regulation of a Eukaryotic Biosynthetic Pathway. Microbiol. Rev. 1991, 55, 349–370. [Google Scholar] [CrossRef]
- Choera, T.; Zelante, T.; Romani, L.; Keller, N.P. A Multifaceted Role of Tryptophan Metabolism and Indoleamine 2,3-Dioxygenase Activity in Aspergillus Fumigatus-Host Interactions. Front. Immunol. 2018, 8, 1–11. [Google Scholar] [CrossRef]
- Kim, M.S.; Kim, S.Y.; Yoon, J.K.; Lee, Y.W.; Bahn, Y.S. An Efficient Gene-Disruption Method in Cryptococcus neoformans by Double-Joint PCR with NAT-Split Markers. Biochem. Biophys. Res. Commun. 2009, 390, 983–988. [Google Scholar] [CrossRef]
- Fernandes, J.D.S.; Martho, K.; Tofik, V.; Vallim, M.A.; Pascon, R.C. The Role of Amino Acid Permeases and Tryptophan Biosynthesis in Cryptococcus neoformans Survival. PLoS ONE 2015, 10, 1–22. [Google Scholar] [CrossRef]
- Nakayashiki, H.; Hanada, S.; Quoc, N.B.; Kadotani, N.; Tosa, Y.; Mayama, S. RNA Silencing as a Tool for Exploring Gene Function in Ascomycete Fungi. Fungal Genet. Biol. 2005, 42, 275–283. [Google Scholar] [CrossRef]
- Toyn, J.H.; Gunyuzlu, P.L.; Hunter White, W.; Thompson, L.A.; Hollis, G.F. A Counterselection for the Tryptophan Pathway in Yeast: 5-Fluoroanthranilic Acid Resistance. Yeast 2000, 16, 553–560. [Google Scholar] [CrossRef]
- Foureau, E.; Clastre, M.; Millerioux, Y.; Simkin, A.J.; Cornet, L.; Dutilleul, C.; Besseau, Ś.; Marais, E.; Melin, Ć.; Guillard, J.; et al. A TRP5/5-Fluoroanthranilic Acid Counter-Selection System for Gene Disruption in Candida guilliermondii. Curr. Genet. 2012, 58, 245–254. [Google Scholar] [CrossRef]
- Cheon, S.A.; Han, E.J.; Kang, H.A.; Ogrydziak, D.M.; Kim, J.Y. Isolation and Characterization of the TRPI Gene from the Yeast Yarrowia lipopolytica and Multiple Gene Disruption Using a TRP Blaster. Yeast 2003, 20, 677–685. [Google Scholar] [CrossRef]
- Cheon, S.A.; Choo, J.; Ubiyvovk, V.M.; Park, J.-N.; Kim, M.W.; Oh, D.-B.; Kwon, O.; Sibirny, A.A.; Kim, J.-Y.; Kang, H.A. New Selectable Host-Marker Systems for Multiple Genetic Manipulations Based on TRP1, MET2 and ADE2 in the Methylotrophic Yeast Hansenula polymorpha. Yeast 2009, 26, 507–521. [Google Scholar] [CrossRef]
- Abe, F.; Hiraki, T. Mechanistic Role of Ergosterol in Membrane Rigidity and Cycloheximide Resistance in Saccharomyces cerevisiae. Biochim. Biophys. Acta Biomembr. 2009, 1788, 743–752. [Google Scholar] [CrossRef]
- Käfer, E. The Anthranilate Synthetase Enzyme Complex and the Trifunctional Trpc Gene of Aspergillus. Can. J. Genet. Cytol. 1977, 19, 723–738. [Google Scholar] [CrossRef]
- Ireland, C.; Peekhaus, N.; Lu, P.; Sangari, R.; Zhang, A.; Masurekar, P.; An, Z. The Tryptophan Synthetase Gene TRP1 of Nodulisporium Sp.: Molecular Characterization and Its Relation to Nodulisporic Acid a Production. Appl. Microbiol. Biotechnol. 2008, 79, 451–459. [Google Scholar] [CrossRef]
- Dörnte, B.; Kües, U. Paradoxical Performance of Tryptophan Synthase Gene Trp1 + in Transformations of the Basidiomycete Coprinopsis cinerea. Appl. Microbiol. Biotechnol. 2016, 100, 8789–8807. [Google Scholar] [CrossRef]
- Yelton, M.M.; Hamer, J.E.; de Souza, E.R.; Mullaney, E.J.; Timberlake, W.E. Developmental Regulation of the Aspergillus nidulans TrpC Gene. Proc. Natl. Acad. Sci. USA 1983, 80, 7576–7580. [Google Scholar] [CrossRef]
- Goosen, T.; van Engelenburg, F.; Debets, F.; Swart, K.; Bos, K.; van den Broek, H. Tryptophan Auxotrophic Mutants in Aspergillus niger: Inactivation of the TrpC Gene by Cotransformation Mutagenesis. MGG Mol. Gen. Genet. 1989, 219, 282–288. [Google Scholar] [CrossRef] [PubMed]
- Horng, J.S.; Linz, J.E.; Pestka, J.J. Cloning and Characterization of the TrpC Gene from an Aflatoxigenic Strain of Aspergillus parasiticus. Appl. Environ. Microbiol. 1989, 55, 2561–2568. [Google Scholar] [CrossRef] [PubMed]
- Eckert, S.E.; Kübler, E.; Hoffmann, B.; Braus, G.H. The Tryptophan Synthase-Encoding TrpB Gene of Aspergillus nidulans Is Regulated by the Cross-Pathway Control System. Mol. Gen. Genet. 2000, 263, 867–876. [Google Scholar] [CrossRef]
- Zalkin, H.Y.C. Yeast Gene TRP5: Structure, Function, Regulation. J. Biol. Chem. 1982, 257, 1491–1500. [Google Scholar] [CrossRef] [PubMed]
- Skrzynia, C.; Binninger, D.M.; Alspaugh, J.A.; Pukkila, P.J. Molecular Characterization of TRP1, a Gene Coding for Tryptophan Synthetase in the Basidiomycete Coprinus Cinereus. Gene 1989, 81, 73–82. [Google Scholar] [CrossRef] [PubMed]
- Hyde, C.C.; Ahmed, S.A.; Padlan, E.A.; Miles, E.W.; Davies, D.R. Three-Dimensional Structure of the Tryptophan Synthase Alpha 2 Beta 2 Multienzyme Complex from Salmonella typhimurium. J. Biol. Chem. 1988, 263, 17857–17871. [Google Scholar] [CrossRef]
- Crawford, I.P.; Clarke, M.; Van Cleemput, M.; Yanofsky, C. Crucial Role of the Connecting Region Joining the Two Functional Domains of Yeast Tryptophan Synthetase. J. Biol. Chem. 1987, 262, 239–244. [Google Scholar] [CrossRef]
- Liang, L.; Li, J.; Cheng, L.; Ling, J.; Luo, Z.; Bai, M.; Xie, B. A High Efficiency Gene Disruption Strategy Using a Positive-Negative Split Selection Marker and Electroporation for Fusarium oxysporum. Microbiol. Res. 2014, 169, 835–843. [Google Scholar] [CrossRef]
- Kück, U.; Hoff, B. New Tools for the Genetic Manipulation of Filamentous Fungi. Appl. Microbiol. Biotechnol. 2010, 86, 51–62. [Google Scholar] [CrossRef]
- Shen, B.; Xiao, J.; Dai, L.; Huang, Y.; Mao, Z.; Lin, R.; Yao, Y.; Xie, B. Development of a High-Efficiency Gene Knockout System for Pochonia chlamydosporia. Microbiol. Res. 2015, 170, 18–26. [Google Scholar] [CrossRef]
- Krappmann, S. Gene Targeting in Filamentous Fungi: The Benefits of Impaired Repair. Fungal Biol. Rev. 2007, 21, 25–29. [Google Scholar] [CrossRef]
- Da Silva Ferreira, M.E.; Kress, M.R.V.Z.; Savoldi, M.; Goldman, M.H.S.; Härtl, A.; Heinekamp, T.; Brakhage, A.A.; Goldman, G.H. The AkuBKU80 Mutant Deficient for Nonhomologous End Joining Is a Powerful Tool for Analyzing Pathogenicity in Aspergillus fumigatus. Eukaryot. Cell 2006, 5, 207–211. [Google Scholar] [CrossRef]
- Krappmann, S.; Sasse, C.; Braus, G.H. Gene Targeting in Aspergillus Fumigatus by Homologous Recombination Is Facilitated in a Nonhomologous End- Joining-Deficient Genetic Background. Eukaryot. Cell 2006, 5, 212–215. [Google Scholar] [CrossRef]
- Ishibashi, K.; Suzuki, K.; Ando, Y.; Takakura, C.; Inoue, H. Nonhomologous Chromosomal Integration of Foreign DNA Is Completely Dependent on MUS-53 (Human Lig4 Homolog) in Neurospora. Proc. Natl. Acad. Sci. USA 2006, 103, 14871–14876. [Google Scholar] [CrossRef]
- Ninomiya, Y.; Suzuki, K.; Ishii, C.; Inoue, H. From The Cover: Highly Efficient Gene Replacements in Neurospora Strains Deficient for Nonhomologous End-Joining. Proc. Natl. Acad. Sci. USA 2004, 101, 12248–12253. [Google Scholar] [CrossRef]
- Jiang, D.; Zhu, W.; Wang, Y.; Sun, C.; Zhang, K.-Q.; Yang, J. Molecular Tools for Functional Genomics in Filamentous Fungi: Recent Advances and New Strategies. Biotechnol. Adv. 2013, 31, 1562–1574. [Google Scholar] [CrossRef]
- Arras, S.D.M.; Chitty, J.L.; Blake, K.L.; Schulz, B.L.; Fraser, J.A. A Genomic Safe Haven for Mutant Complementation in Cryptococcus neoformans. PLoS ONE 2015, 10, 1–16. [Google Scholar] [CrossRef]
- Fan, Y.; Lin, X. An Intergenic “Safe Haven” Region in Cryptococcus neoformans Serotype D Genomes. Fungal Genet. Biol. 2020, 144, 103464. [Google Scholar] [CrossRef]
- Brand, A.; MacCallum, D.M.; Brown, A.J.P.; Gow, N.A.R.; Odds, F.C. Ectopic Expression of URA3 Can Influence the Virulence Phenotypes and Proteome of Candida albicans but Can Be Overcome by Targeted Reintegration of URA3 at the RPS10 Locus. Eukaryot. Cell 2004, 3, 900–909. [Google Scholar] [CrossRef]
- Staats, C.C.; Junges, A.; Fitarelli, M.; Furlaneto, M.C.; Vainstein, M.H.; Schrank, A. Gene Inactivation Mediated by Agrobacterium tumefaciens in the Filamentous Fungi Metarhizium anisopliae. Appl. Microbiol. Biotechnol. 2007, 76, 945–950. [Google Scholar] [CrossRef]
- Wang, P.-M.; Choera, T.; Wiemann, P.; Pisithkul, T.; Amador-Noguez, D.; Keller, N.P. TrpE Feedback Mutants Reveal Roadblocks and Conduits toward Increasing Secondary Metabolism in Aspergillus fumigatus. Fungal Genet. Biol. 2016, 89, 102–113. [Google Scholar] [CrossRef] [PubMed]
- Carsiotis, M.; Jones, R.F. Cross-Pathway Regulation: Tryptophan-Mediated Control of Histidine and Arginine Biosynthetic Enzymes in Neurospora crassa. J. Bacteriol. 1974, 119, 889–892. [Google Scholar] [CrossRef] [PubMed]
- Tian, C.; Kasuga, T.; Sachs, M.S.; Glass, N.L. Transcriptional Profiling of Cross Pathway Control in Neurospora crassa and Comparative Analysis of the Gcn4 and CPC1 Regulons. Eukaryot. Cell 2007, 6, 1018–1029. [Google Scholar] [CrossRef] [PubMed]
- Braus, G.H.; Sasse, C.; Krappmann, S. Amino Acid Acquisition, Cross-Pathway Control, and Virulence in Aspergillus. Med. Mycol. 2006, 44, 91–94. [Google Scholar] [CrossRef] [PubMed]
- Perkins, D.D.; Radford, A.; Newmeyer, D.; Björkman, M. Chromosomal Loci of Neurospora crassa. Microbiol. Rev. 1982, 46, 426–570. [Google Scholar] [CrossRef]
- Prabha, V.L.; Punekar, N.S. Genetic Transformation in Aspergilli: Tools of the Trade. Indian J. Biochem. Biophys. 2004, 41, 205–215. [Google Scholar]
- Meyer, V. Genetic Engineering of Filamentous Fungi—Progress, Obstacles and Future Trends. Biotechnol. Adv. 2008, 26, 177–185. [Google Scholar] [CrossRef]
- Olmedo-Monfil, V.; Cortés-Penagos, C.; Herrera-Estrella, A. Three Decades of Fungal Transformation: Key Concepts and Applications. Methods Mol. Biol. 2004, 267, 297–313. [Google Scholar] [CrossRef]
- Amich, J.; Bignell, E. Amino Acid Biosynthetic Routes as Drug Targets for Pulmonary Fungal Pathogens: What Is Known and Why Do We Need to Know More? Curr. Opin. Microbiol. 2016, 32, 151–158. [Google Scholar] [CrossRef]
- Sasse, A.; Hamer, S.N.; Amich, J.; Binder, J.; Krappmann, S. Mutant Characterization and in Vivo Conditional Repression Identify Aromatic Amino Acid Biosynthesis to Be Essential for Aspergillus fumigatus Virulence. Virulence 2016, 7, 56–62. [Google Scholar] [CrossRef]
- Geisler, S.; Mayersbach, P.; Becker, K.; Schennach, H.; Fuchs, D.; Gostner, J.M. Serum Tryptophan, Kynurenine, Phenylalanine, Tyrosine and Neopterin Concentrations in 100 Healthy Blood Donors. Pteridines 2015, 26, 31–36. [Google Scholar] [CrossRef]
- Dias, M.V.B.; Canduri, F.; da Silveira, N.J.F.; Czekster, C.M.; Basso, L.A.; Palma, M.S.; Santos, D.S.; de Azevedo, W.F. Molecular Models of Tryptophan Synthase from Mycobacterium tuberculosis Complexed with Inhibitors. Cell Biochem. Biophys. 2006, 44, 375–384. [Google Scholar] [CrossRef]
- Naz, S.; Farooq, U.; Ali, S.; Sarwar, R.; Khan, S.; Abagyan, R. Identification of New Benzamide Inhibitor against α -Subunit of Tryptophan Synthase from Mycobacterium tuberculosis through Structure-Based Virtual Screening, Anti-Tuberculosis Activity and Molecular Dynamics Simulations. J. Biomol. Struct. Dyn. 2019, 37, 1043–1053. [Google Scholar] [CrossRef]

| Enzymatic Function | Protein Name /Gene ID | F. pedrosoi transcript ID e | % Amino acid identity f | |||
|---|---|---|---|---|---|---|
| S. cerevisiaea | C. neoformansb | A. fumigatusc | F. pedrosoid | |||
| Anthranilate synthase component I-Chorismate aminase [EC:4.1.3.27] | Trp2 YER090W | Trp2 CNAG_06679 | TrpE Afu6g12580 | TrpEZ517_08726 | KIW78887 | 70.98 |
| Anthranilate synthase component II-Glutamine amidotransferase/Phosphoribosyl-anthranilate isomerase/Indoleglycerol phosphate synthase [EC:4.1.3.27 4.1.1.48] | Trp3 YKL211C | Trp3 CNAG_04501 | TrpC Afu1g13090 | TrpCZ517_05805 | -KIW79193 | 66.49 |
| Anthranilate phosphoribosyl transferase [EC:2.4.2.18] | Trp4 YDR354W | Trp4 CNAG_00811 | TrpD Afu4g11980 | TrpDZ517_01180 | -KIW85788 | 63.84 |
| Phosphoribosylanthranilate isomerase [EC:5.3.1.24] | Trp1 YDR007W | Trp3 CNAG_04501 | TrpC Afu1g13090 | TrpCZ517_05805 | -KIW79193 | 66.49 |
| Tryptophan synthase [EC:4.2.1.20] | Trp5 YGL026C | Trp5 CNAG_00649 | TrpB Afu2g13250 | TrpBZ517_07968 | -KIW78135 | 78.39 |
Disclaimer/Publisher’s Note: The statements, opinions and data contained in all publications are solely those of the individual author(s) and contributor(s) and not of MDPI and/or the editor(s). MDPI and/or the editor(s) disclaim responsibility for any injury to people or property resulting from any ideas, methods, instructions or products referred to in the content. |
© 2023 by the authors. Licensee MDPI, Basel, Switzerland. This article is an open access article distributed under the terms and conditions of the Creative Commons Attribution (CC BY) license (https://creativecommons.org/licenses/by/4.0/).
Share and Cite
Favilla, L.D.; Herman, T.S.; Goersch, C.d.S.; de Andrade, R.V.; Felipe, M.S.S.; Bocca, A.L.; Fernandes, L. Expanding the Toolbox for Functional Genomics in Fonsecaea pedrosoi: The Use of Split-Marker and Biolistic Transformation for Inactivation of Tryptophan Synthase (trpB) Gene. J. Fungi 2023, 9, 224. https://doi.org/10.3390/jof9020224
Favilla LD, Herman TS, Goersch CdS, de Andrade RV, Felipe MSS, Bocca AL, Fernandes L. Expanding the Toolbox for Functional Genomics in Fonsecaea pedrosoi: The Use of Split-Marker and Biolistic Transformation for Inactivation of Tryptophan Synthase (trpB) Gene. Journal of Fungi. 2023; 9(2):224. https://doi.org/10.3390/jof9020224
Chicago/Turabian StyleFavilla, Luísa Dan, Tatiana Sobianski Herman, Camila da Silva Goersch, Rosangela Vieira de Andrade, Maria Sueli Soares Felipe, Anamélia Lorenzetti Bocca, and Larissa Fernandes. 2023. "Expanding the Toolbox for Functional Genomics in Fonsecaea pedrosoi: The Use of Split-Marker and Biolistic Transformation for Inactivation of Tryptophan Synthase (trpB) Gene" Journal of Fungi 9, no. 2: 224. https://doi.org/10.3390/jof9020224
APA StyleFavilla, L. D., Herman, T. S., Goersch, C. d. S., de Andrade, R. V., Felipe, M. S. S., Bocca, A. L., & Fernandes, L. (2023). Expanding the Toolbox for Functional Genomics in Fonsecaea pedrosoi: The Use of Split-Marker and Biolistic Transformation for Inactivation of Tryptophan Synthase (trpB) Gene. Journal of Fungi, 9(2), 224. https://doi.org/10.3390/jof9020224

